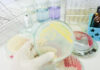
Новый ГОСТ по исследованию племенной продукции вступил в силу 1 июля

В Госдуме РФ принят в первом чтении законопроект: производителей могут обязать регистрировать собственные стандарты и технические условия в Федеральном информационном фонде.
Законопроект внесен депутатской группой во главе с вице-спикером Алексеем Гордеевым. Парламентарии предлагают с помощью нового закона повысить безопасность продукции, производимой по собственным стандартам и техническим условиям организаций.
Первый зампредседателя Комитета Госдумы по экономической политике Надежда Школкина, один из авторов законопроекта:
Законопроект предлагает создание равных условий для всех производителей, независимо от того, по каким стандартам они выпускают свою продукцию – по ГОСТу или техническим условиям, а именно: в случае публичного заявления производителем о выпуске продукции в соответствии со стандартом организации или техническими условиями такой стандарт должен быть зарегистрирован в Федеральном информационном фонде стандартов, содержащем данные обо всех действующих в стране стандарта
Проверять внутренние стандарты и технические условия поручат Росстандарту.
«Единая Россия» сообщает, что «стандарты продукции, на которой указано о соответствии стандартам организаций и техническим условиям (СТО/ТУ), обязаны регистрироваться в Федеральном информационном фонде. Сейчас регистрация носит добровольный характер».
Надежда Школкина считает, что единая база стандартов может стать «подспорьем для многих производителей, в том числе как при строительстве нового производства, так и в поисках необходимого поставщика или недостающей запчасти к оборудованию… Такой фонд стандартов позволит… розничным сетям еще в начале… закупки не допустить на полку магазина фальсифицированную продукцию, например, произведенную по стандарту организации, которого даже не существует в природе».
Если законопроект будет принят, он вступит в силу через 180 дней после официальной публикации.